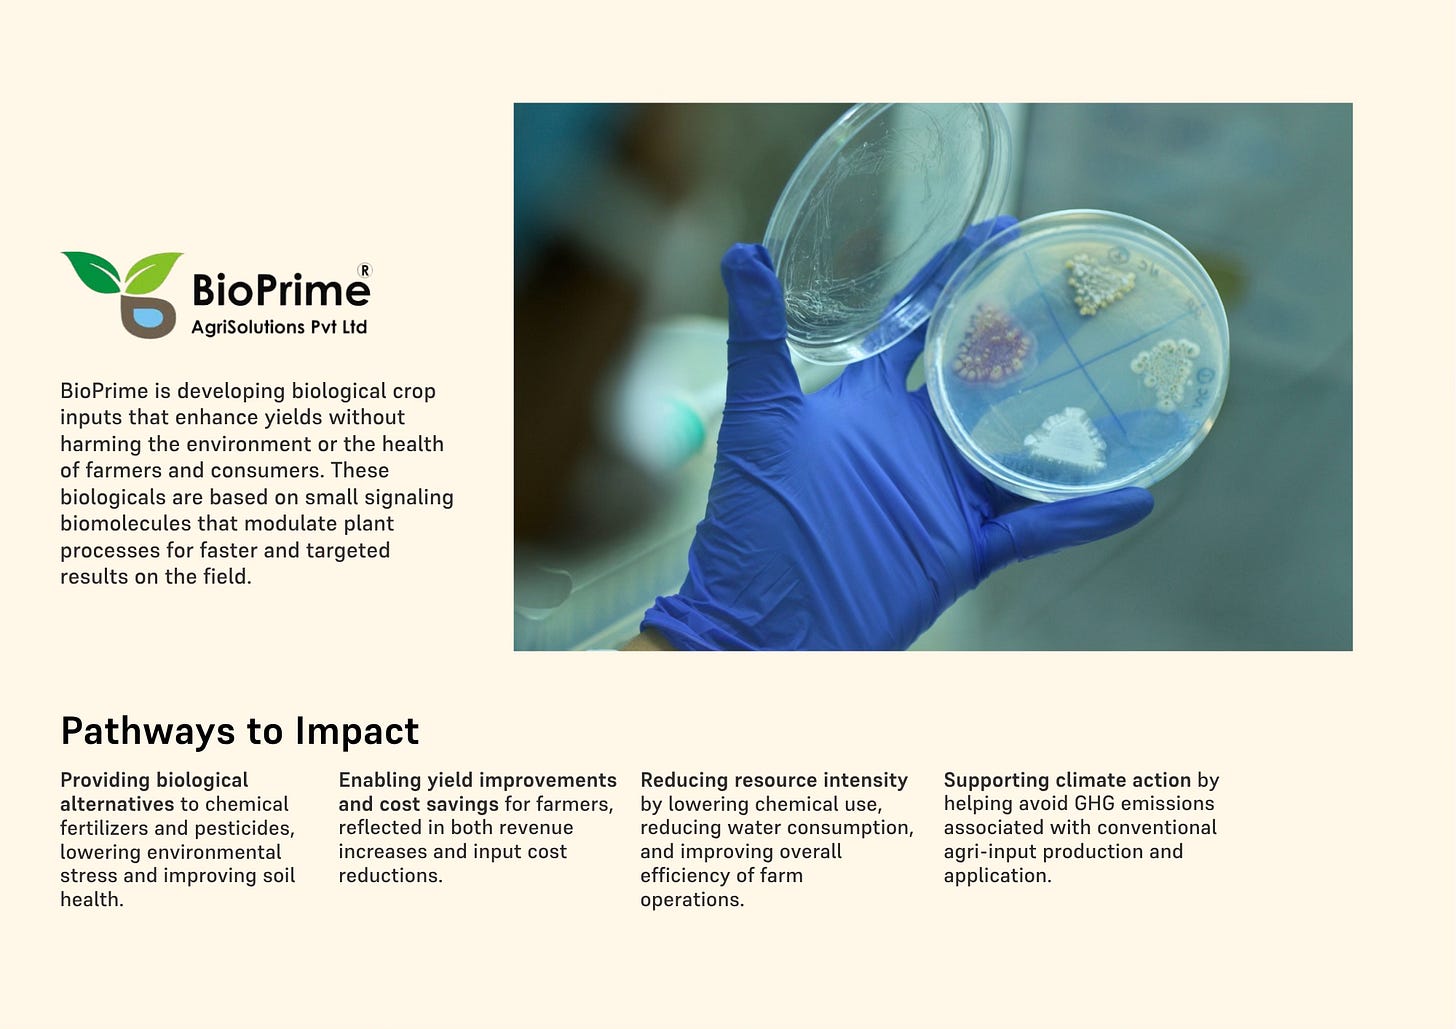

Accelerating homegrown deep-tech to better utilise India’s resources
Bharat’s path to strategic autonomy through tech investments beyond AI

In the past few weeks, the conflict in West Asia has exposed India and other Asian countries to the risk of fuel and energy shortages. A prolonged conflict would also mean rising food insecurity, higher costs of living, and extreme shortages of fossil fuels that are the fundamental building blocks of our everyday utilities - from electricity to materials and transportation.
During this time, as a country, we’ve been firsthand witnesses of how geopolitical shocks can affect the lives of common people.
When LPG supply is at risk; hotel chains and restaurants have to shrink their menus; household cooking decisions have to be more calculated and something as fundamental as a chapati suddenly becomes a luxury.
But that’s not all. As has already been covered in many headlines in the past weeks; the current geopolitical unrest also exposes us to severe industrial consequences. In agriculture, for example, the supply of crop inputs that are crucial for food production is endangered. The government had to step up and secure supply lines to ensure food productivity for the upcoming Kharif season.
India imports around 77% of the natural gas it needs just to produce domestic urea. It relies entirely on imported potash, and nearly 90% of its DAP comes from abroad.
Roughly a third of global seaborne fertiliser trade passes through the Strait of Hormuz, including nearly half the world’s urea. The fertiliser subsidy bill, the government’s buffer between global price shocks and Indian farmers, peaked at ≈ $30–31 billion USD in 2022-23 and is projected at ≈ $22.5–23 billion USD for FY26.
Beyond agriculture, India imports roughly 85% of its crude oil, spending over $100 billion on petroleum annually. Industrial chemicals, construction materials, synthetic textiles - the inputs that keep factories running and cities building are overwhelmingly petrochemical in origin, and therefore overwhelmingly imported.
None of this is an argument against global trade. The interdependence of supply chains is not a flaw in the system: it is, in large part, what has made modern economic growth possible.
Fossil fuels have powered the most extraordinary expansion of human prosperity in history. The fertiliser chemistry that came out of the Haber-Bosch process has fed billions. The petrochemical industry underpins nearly every material comfort of contemporary life. India is rightly part of this global network, and will remain so. Retreating from it entirely is neither desirable nor realistic.
What a crisis like this one does, however, is sharpen a different question. The question is not whether India should trade globally (it should). The question is how many of its most critical inputs have no domestic substitutes whatsoever. How many points in the supply chain, if disrupted, leave the country with no fallback. That degree of exposure is not an inevitable consequence of participating in global trade. It is a consequence of not having built enough at home.
We brought together three founders who are doing exactly that: developing functional, homegrown alternatives across three of India’s most exposed input categories.
Dr. Renuka Diwan of BioPrime is building biological alternatives to chemical fertilisers from India’s own soils, its own microbial ecosystems, its own agro-climatic diversity.
Apoorv Garg of AltM is converting agricultural residue and any kind of lignocellulosic biomass (the hundreds of millions of tonnes India burns every harvest season) into industrial-grade materials that compete directly with petrochemical derivatives.
Manya Ranjan of Two Point O Capital is building the financial infrastructure that allows India’s Commercial and Industrial customers, including the 63 million small and medium businesses, to access latest clean technologies, both on the energy supply and demand side, reducing their dependence on imported fossil fuels, one installation at a time.
Part One - India’s Invisible Biodiversity
Dr. Renuka Diwan - Co-founder & CEO, BioPrime
Q: What is the structural problem in India’s fertiliser system that BioPrime is trying to solve?
Indian agriculture runs on synthetic fertilisers. Urea, DAP and MOP are the primary sources of crop nutrition - a monoculture reality shaped by the Green Revolution. This dependence has created a structural vulnerability that is now impossible to ignore. The fiscal weight of being solely and heavily dependent on chemical fertilizers is huge (≈ $22.5–23 billion USD) projected for this year alone). So there is a real opportunity to increase agricultural output while reducing fertilizer dependence by integrating homegrown bio-based substitutes into the input cycle.
The agronomic side of the picture is equally troubling. urea is sold at a fixed administered price of ₹242 per 45 kg bag (unchanged since March 2018), making nitrogen artificially cheap relative to other nutrients. Farmers, applying fertiliser based on habit and cost rather than soil test results, reach for the cheapest input by default. India’s actual NPK application ratio in Kharif 2024 stood at approximately 9.8:3.7:1 - far from the recommended benchmark of 4:2:1. Nitrogen is dramatically over-applied; potash is chronically under-used.
Q: How is BioPrime’s science different from conventional biological inputs?
There are three separate bottlenecks in nutrient use efficiency: availability, uptake, and utilisation, and most products in the market address only one or two. Improving only nutrient availability is like widening a road to a city with a closed gate. BioPrime works on the road, the gate and the city’s capacity to absorb what arrives.
BioPrime’s fertiliser bioadditives operate across all three bottlenecks simultaneously, enhancing nutrient solubilisation in the root zone, activating root physiology and nutrient transporter pathways, and stimulating the plant’s internal metabolic pathways. The combined effect produces NUE improvements of 20–25 per cent across nitrogen, phosphorus and potassium simultaneously. Farmers can reduce fertiliser application by 20-25 per cent while maintaining or improving yields.
India also has a specific phosphorus challenge. Our soils contain a disproportionate share of phosphorus bound in complex mineral forms: aluminium-bound, iron-bound, rock phosphate that are far harder to solubilise than the simpler forms prevalent elsewhere. BioPrime has developed PSB strains that are, to our knowledge, the only strains with demonstrated capacity to solubilise phosphorus from these complex matrices, delivering 2–3 times the activity of conventional commercial strains.
Q: What makes India specifically the right place to build this?
India’s extraordinary agro-climatic diversity has produced one of the richest reservoirs of plants and plant-associated microbial life on earth.
BioPrime has systematically mapped and collected from this natural wealth, building what is now the largest plant-associated microbe library in India. This library is a competitive moat that cannot be replicated quickly: it took years of field collection, screening and characterisation to build.
India’s agricultural diversity also functions as an unusually rigorous proving ground. A product that works reliably across India’s complexity of crops, soil types and climate regimes tends to work everywhere; an underappreciated competitive advantage in global markets.
Q: In the event of a supply disruption, how does BioPrime’s solution change the equation?
A 10 per cent shortfall in fertiliser supply results in yield drops of 20 per cent or more in nutrient-dependent crops. BioPrime’s solution inverts this relationship. If farmers across India’s kharif belt have access to NUE-enhancing bioadditives before the season, the country effectively builds a 20–25 per cent efficiency buffer into its fertiliser system — enough to absorb moderate import disruptions without yield loss.
At scale, this means a disruption event that would have caused catastrophic food production shortfalls instead becomes manageable. Food prices remain anchored. Rural incomes are protected. Over 85 per cent of India’s 140 million farm holdings are smaller than two hectares. For these farmers, the impact is direct: lower input cost, higher output, and produce that commands ₹2–3 per kilogram more at the farm gate. At scale, they constitute a form of agricultural sovereign resilience that no amount of import diversification or subsidy expansion can provide on its own.
Part Two: The Value in What We Burn
Apoorv Garg - Co-founder & CEO, AltM
Q: What is the industrial vulnerability that AltM is trying to address?
One of the most exposed parts of India’s industrial supply chains is not always visible. A large share of the materials that underpin everyday products: from adhesives and coatings to textiles and construction inputs, originate from a narrow set of petrochemical building blocks. These supply chains are efficient, but deeply import-dependent, and therefore vulnerable to the same disruptions that affect energy and fertilisers.
Reducing that exposure does not require replacing these systems entirely. It requires identifying where equivalent materials can be produced from domestic resources, and building the capability to do so at scale.
Q: Where does India’s domestic opportunity actually lie?
India already produces the raw material for this transition in abundance. Every year, hundreds of millions of tonnes of biomass are generated, a significant portion of which is burned due to the absence of viable end uses. Within this biomass are cellulose and lignin — two biopolymers that contain similar fundamental chemical structures to what industry currently derives from fossil sources.
The opportunity is not in treating this as waste to be managed, but as a feedstock to be engineered. Lignin, in particular, is the largest renewable source of aromatic carbon available today. Converting it into usable industrial intermediates has been a longstanding challenge: not because of a lack of scientific understanding, but because existing processes were not designed for the variability and composition of Indian feedstocks.
Q: What has AltM built, and what makes it specific to India?
Our work has focused on closing that gap. The approach has been to build thermochemical processes specifically around agricultural and industrial bio-residues such as rice straw, sugarcane bagasse and biorefinery waste. This allows us to produce functional materials that can directly substitute petrochemical-derived inputs in industrial applications, while meeting the same performance and cost requirements.
What determines whether this shift scales is not the chemistry alone. It is the ability to align process design, feedstock supply chains, and industrial adoption from the outset. When that alignment holds, what is currently burned as residue begins to function as part of the materials economy.
Q: What is the broader significance of getting this right?
Biomass is not just an agricultural byproduct. It is one of the clearest opportunities India has to build resilient domestic supply chains in a segment that remains heavily exposed to external shocks. In that sense, the transition from imported petrochemical inputs to domestically produced bio-based materials is not simply an environmental proposition. It is an industrial sovereignty argument — and the feedstock to make it real is already here.
Part Three - Distributing Energy Independence
Manya Ranjan - Co-founder & CBO/COO, Two Point O Capital
Q: What is the gap in India’s clean energy transition that Two Point O is trying to close?
Emissions from the Commercial and Industrial sector account for over 50% of total emissions. Yet this sector remains largely underserved: climate focus has predominantly been on residential or utility-scale projects, often assuming C&I entities can self-fund their transition. This is a critical gap. Numerous bankable projects fail to launch not because the economics are unclear, but because specialised capital does not exist to finance them. With a potential market exceeding $100 billion annually in India, Two Point O Capital is built to bridge this gap.
Q: How does geopolitical instability make this more urgent?
The latest shocks from West Asia underscore the urgent need for a more resilient and domestically secured energy sector. With a reliance on imports for 85% of our oil and 50% of our gas, India is profoundly vulnerable to supply disruptions. Recent price volatility threatens inflation targets, fiscal deficits, and industrial competitiveness — risking the vision of self-reliant prosperity that underpins India’s ambition to become a developed nation by 2047.
India’s most viable path is to double down on electricity: our most promising indigenous energy source, and accelerate the electrification of all end-use sectors. This allows us to build a robust economy leveraging our own resource abundance. The C&I sector is where that shift needs to happen fastest, and where capital has been most absent.
Q: What does Two Point O’s solution actually look like in practice?
We provide innovative financing that couples best-in-class capital with the latest clean technologies: solar, battery storage, energy efficiency, and wastewater treatment; delivering 20–50% operational savings for customers alongside a 30–50% reduction in carbon emissions. Critically, we guarantee outcomes and transfer the risk of optimised asset operations from the customer to us. The approach is fully end-to-end, so the customer experiences a frictionless transition to clean technology without upfront capital burden.
This product does not exist in the Indian market today. Two Point O Capital is building it so that India’s C&I sector does not need to think twice about adopting the latest clean technologies.
Q: Why was this not possible ten years ago, and what has changed?
Three factors have transformed the landscape. First, the underlying technologies - high-efficiency solar modules, lithium-ion storage, advanced heat pumps have seen exponential improvements in performance.
Second, increased deployment scale has driven costs down dramatically, with cleantech now following a trajectory similar to Moore’s Law. Third, digital infrastructure now enables us to remotely underwrite, deploy and operate distributed assets with an optimised, efficient footprint, something that was operationally impossible a decade ago.
Together, these shifts have made it viable to finance distributed clean energy assets for businesses that mainstream capital has historically found too small, too technical, or too dispersed to serve.
Part 4 - The Case for Strategic Autonomy
Abhilash Sethi - Partner, Omnivore
Strategic autonomy, in its simplest form, is a country’s ability to make consequential choices without being held hostage by what it cannot produce. It is not autarky; the goal is not to make everything domestically. It is leverage: enough domestic capability in enough critical inputs that no single supply shock, no single geopolitical rupture, can remove a choice from the table. For an economy of India’s scale and ambition, that condition is not optional. It has to be built.
Building it, however, requires capital to move toward it. And right now, capital is largely looking elsewhere.
The dominant narrative of this decade is digital; AI, software, platforms. These are legitimate and important. But they are not the only frontier moving.
Biology is advancing as fast as compute. It’s also advancing alongside compute. Materials science is being re(written) by new bio-processing technologies. Energy systems are being rebuilt from the ground up. The tools available to founders working in these domains today: in molecular biology, in thermochemical engineering, in climate finance, are categorically different from what existed a decade ago.
So when a corridor closes halfway across the world and input prices move within days, the argument for building domestic capability becomes visceral. The three founders in this piece are working on different problems with different tools. But the investment logic connecting them is the same. Each looked at something India was spending billions importing - crop nutrition, industrial materials, energy inputs and asked whether it could be produced from what India already has. Each found that the answer was yes. And each chose to build the capability to make it so.
That choice is harder than it sounds. Renuka is working with soil biology that took millions of years to develop. Apoorv is building thermochemical processes that had to be redesigned from scratch for Indian feedstocks. Manya is financing assets that mainstream capital has consistently walked past. None of this is straightforward. None of it scales quickly. All of it is necessary.
India has the biomass, the biodiversity, the sunlight and the scientific talent. What it needs is more founders willing to build from those resources, and more capital willing to scale domestic capabilities. The companies in this piece are proof that building strategic autonomy is possible. The question is how much enablement will follow.